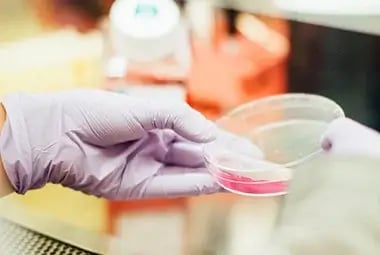
chemical-industry-hype-innovation

Automotive & Transportation
Airbus, Autoneum Management, Bombardier, Borbet, Brose, Claas, Continental, Daimler, Stora Enso, DLR, Huf Group, Mahle, Pierburg, Volvo Group, VW, Toyota
HYPE has been chosen by some of the most innovative companies from around the world. And we would love to be your partner too. But don't listen to us. Listen to our clients.



Airbus, Autoneum Management, Bombardier, Borbet, Brose, Claas, Continental, Daimler, Stora Enso, DLR, Huf Group, Mahle, Pierburg, Volvo Group, VW, Toyota
Baxi Genuine Parts, EagleBurgmann, Liebherr, Maschinenfabrik Reinhausen, Maxion Wheels, ThyssenKrupp, Wafios, Wieland, Siemens, Wilo, Witzenmann


Bayer, Cilag, Constantia, Grünenthal, Merck, Olympus, Roche, Straumann, YPSOMED, W.O.M. World of Medicine, Aesculap

Head, Mattel, Essity Hygiene and Health AB, Stora Enso, Ricola, Wepa
AkzoNobel, BASF, Kanzan, Knauf, Sika, Sipchem, Sto, Stora Enso, Wacker

BST Corp, Die Mobiliar, Munich RE, Riyad Bank, ConocoPhillips Alaska, SIX Group, Techniker Krankenkasse
Dubai Electricity And Water Authority (DEWA), Gasco, GRDF, Innogy Consulting GmbH, Romande Energie SA, RWE, Saudi Aramco, Veolia, Worley Parsons


Deutsche Post DHL, Equiniti ICS, GfK, Interserve, Liberty Global, Neopost, PwC, Ricoh New Zealand Limited, UC San Diego
See how Fujitsu uses HYPE's platform to work with their customers on co-creation projects.
We make software that helps companies connect people with ideas, to drive innovation and transformation forward.

Please keep me posted on Hype’s latest new product features and innovation management insights.